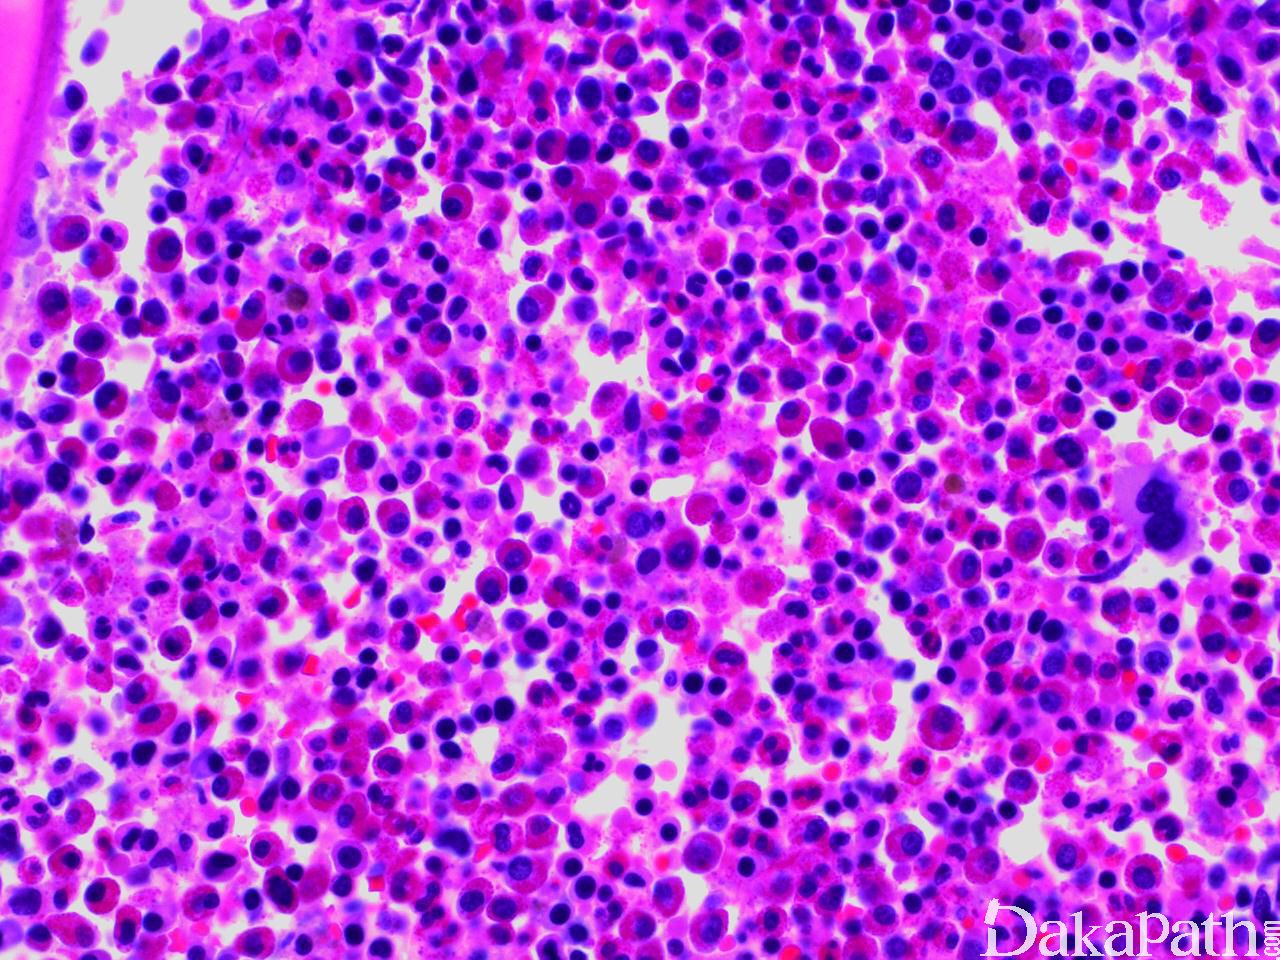

慢性嗜酸性粒细胞白血病,非特指
Chronic Eosinophilia Leukemia, Not Otherwise Specified(CEL,NOS)
同义词(或曾用名): 慢性嗜酸细胞白血病
概述:
慢性嗜酸性粒细胞白血病是一种髓系增殖性肿瘤,其特征为嗜酸性粒细胞克隆性增生,累及外周血、骨髓和髓外组织,并导致器官如心脏、肺、中枢神经、皮肤、胃肠道、脾、肝等损害。
诊断要点:
1. 临床表现和形态学
有时无症状而无意中发现。一些病例可表现为体重减轻、盗汗、发热、乏力、咳嗽、血管水肿、肌肉痛、瘀斑、腹泻等,最严重的表现为心内膜纤维化导致限制性心脏肥大。
CEL NOS 最突出的特征是外周血嗜酸细胞增高,主要为成熟细胞,仅有少量嗜酸性中幼粒细胞或早幼粒细胞。可有不同程度的嗜酸细胞异型,包括颗粒稀少(胞质透明区),胞质空泡,核分叶过多或减少及核增大。但这些改变都可见于反应性嗜酸细胞增多,对诊断没有帮助。偶尔 CEL NOS 嗜酸细胞形态正常,但无异型增生通常支持反应性改变。
常伴中性粒细胞增多,有时伴单核细胞增多,伴轻度嗜碱性粒细胞增高也有报道。可以见到原始细胞,但<20%。
骨髓细胞密度增加,部分原因为嗜酸细胞增生,大多数病例嗜酸细胞分化成熟正常。红系和巨核系一般正常。
母细胞比例增高(5-19%)支持 CEL,NOS;同样,其它系异型增生也支持 CEL,NOS。
1/3 病例伴骨髓纤维化,但严重的骨髓纤维化少见。
2. 诊断标准(2017 年版 WHO )
外周血嗜酸性粒细胞计数 ≥1.5x109/L;
不满足 WHO BCR-ABL1 阳性 CML、真性红细胞增多症、原发性骨髓纤维化、慢性中性粒细胞白血病、慢性粒单细胞白血病、不典型髓系白血病的诊断标准;
无 PDGFRA、PDGFRB、FGFR1 重排,无 PCM1-JAK2. ETV6-JAK2. 或 BCR-JAK2 融合;
外周血及骨髓中母细胞< 20%,且无 inv(16)(p13q22)或 t(16;16)(p13;q22)或 t(8;21)
(q22;q22.1),无其它对 AML 具有诊断意义的特征;
- 有克隆性细胞遗传学异常或分子遗传学异常 a,或外周血母细胞 ≥2%,或骨髓母细胞 ≥5%。
同时满足上述 5 条方可确诊 CEL NOS。
※a 因为一些克隆性分子遗传学异常(如 TET2. ASXL1. DNMT3A 突变)也可见于少数无明显血液学异常的老龄人,因此在仅凭分子克隆诊断老龄人慢性嗜酸细胞白血病前应该排除其他原因引起的反应性嗜酸细胞增多。
3. 细胞遗传学
无特异性遗传学异常,但重现性髓系肿瘤核型异常如+8. -7. i(17q)等支持 CEL,NOS 的诊断。
4. 预后
相差很大,急性转化常见,预后差。
鉴别诊断:
1. 反应性嗜酸性粒细胞增多 :很多原因都可以引起发应性嗜酸性粒细胞增高,如寄生虫感染、过敏反应、内分秘疾病、肺 loffler 综合征,皮肤病如血管淋巴增生、胶原血管病、Kimura 病,一些肿瘤如 T 细胞淋巴瘤、霍奇金淋巴瘤、系统性肥大细胞增多症、淋巴母细胞白血病及其它 MPN 等。
2. 原发性嗜酸细胞增多综合征 :诊断标准 1)外周血嗜酸细胞 ≥1.5x109/L,持续 ≥6 个月;2)彻底检查排除反应性嗜酸性粒细胞增多;3)排除 AML、MPN、MDS、MDS/MPN、系统性肥大细胞增多症;4)排除产生细胞因子、免疫表型异常的 T 细胞群;5)嗜酸细胞增多引起组织损伤。如果满足上述 1-4 条,无组织损伤应诊断原发性嗜酸细胞增多。
3. 其它伴有嗜酸性粒细胞增高或增生的淋巴造血系统肿瘤 :如淋系与髓系肿瘤伴 PDGFRA 或 FGFR1 重排,髓系肿瘤伴 PDGFRA 重排、MPN、MDS/MPN、霍奇金淋巴瘤、T 细胞肿瘤、淋巴母细胞白血病伴 t(5;14)等。